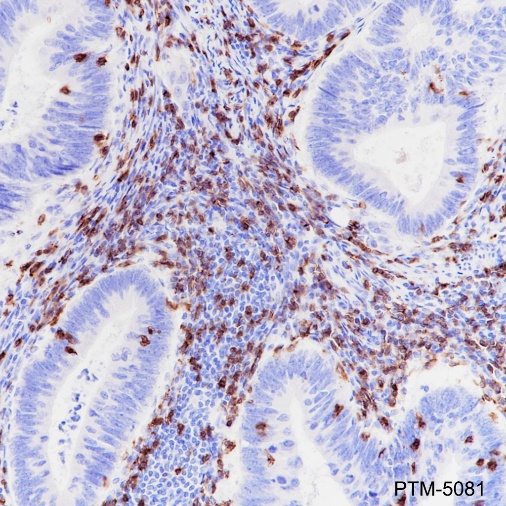

Background
CD8a is an integral membrane glycoprotein that plays an essential role in the immune response and serves multiple functions in responses against both external and internal offenses. In T-cells, CD8a serves primarily as a coreceptor for MHC class I molecule: peptide complex and its function are involved with lymphokine production, motility, adhesion and activation of cytotoxic T-lymphocytes (CTLs). In NK-cells, the presence of CD8a homodimers at the cell surface provides a survival mechanism allowing conjugation and lysis of multiple target cells. CD8a homodimer molecules also promote the survival and differentiation of activated lymphocytes into memory CD8 T-cells.
Cellular location
Secreted and membrane